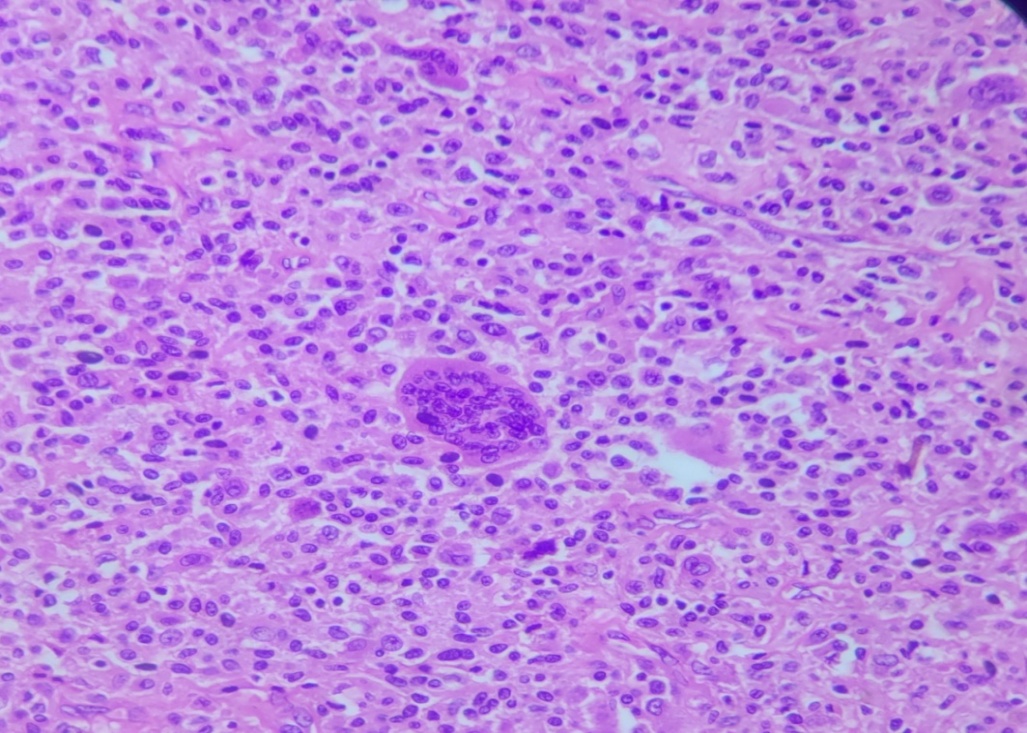

Int J Curr Pharm Res, Vol 16, Issue 4, 132-134Case Study
GIANT CELL TUMOUR OF TENDON SHEATH IN THE FOOT: A RARE CASE REPORT
GIRISH GARG, RAGHUVEER MEENA*, SANDEEP KUMAR, MAHAVEER MEENA
Department of Orthopaedics, Jhalawar Medical College, Jhalawar, Rajasthan, India
*Corresponding author: Raghuveer Meena; *Email: drmahaveer@gmail.com
Received: 10 Apr 2024, Revised and Accepted: 02 Jun 2024
ABSTRACT
Giant cell tumor of the tendon sheath (GCT-TS) is predominantly encountered in the hand, ranking as the second most common solid tumor after ganglion cysts. Contrary to its prevalence in the upper extremity, GCT-TS manifestation in the foot is exceptionally rare. This report delineates a unique presentation of GCT-TS in the foot of a 25 y old female, who presented with a painful, progressively enlarging mass in the lateral aspect of her foot. This case underscores the diagnostic challenges and therapeutic considerations in managing such an atypical presentation of GCT-TS.
Keywords: Giant cell tumour
© 2024 The Authors. Published by Innovare Academic Sciences Pvt Ltd. This is an open access article under the CC BY license (https://creativecommons.org/licenses/by/4.0/)
DOI: https://dx.doi.org/10.22159/ijcpr.2024v16i4.4093 Journal homepage: https://innovareacademics.in/journals/index.php/ijcpr
INTRODUCTION
Giant cell tumor of the tendon sheath (GCT-TS), historically recognized alongside pigmented villonodular synovitis and pigmented villonodular bursitis in a continuum of related lesions, has been reclassified based on contemporary clinical and histological evidence as a distinct neoplastic entity [1, 2]. Characterized by its benign, albeit locally aggressive nature, GCT-TS predominantly affects the tendons of the hand, with a notable predisposition for recurrence post-excision [3]. Its occurrence in the foot, however, remains an anomaly, with the literature offering limited insight into its behavior and optimal management strategies in this locale [4]. The case discussed herein highlights a significant presentation of GCT-TS in the foot, marked by a substantial size attributed to its prolonged undetected progression [5].
CASE REPORT
A 25 y old female sought evaluation for a painful mass on the lateral aspect of her left foot, first noted three y prior. The mass had shown a rapid increase in size over the preceding three months, exacerbating the patient's discomfort and impairing ambulation. Physical examination revealed a 4 cm x 3 cm mass situated below the lateral malleolus on the dorsum of the foot, characterized by tenderness, firm consistency, and fixed positioning without associated neurological deficits.
Diagnostic imaging, including an X-ray, identified a soft tissue swelling adjacent to the lateral cuneiform and base of the 5th metatarsal, with no evidence of bone involvement. Comprehensive serological evaluation yielded unremarkable results. Differential diagnoses considered encompassed GCT-TS, synovial sarcoma, tuberculosis, and pigmented villonodular synovitis.
Surgical intervention entailed an excisional biopsy of the mass, revealing its origin from the peroneus tendon sheath. The excised specimen was rubbery, multilobulated, measuring 5x3 cm, and exhibited a dark red to brown hue indicative of haemosiderin deposition. Microscopic examination confirmed the diagnosis of GCT-TS, evidenced by the presence of multinucleated giant cells and foam cells.

Fig. 1: Clinical picture

Fig. 2: Pre-op xray

Fig. 3: Intra op photo

Fig. 4: GCT-TS

Fig. 5: Post-op xray

Fig. 6: Hemosiderin pigmentation
Fig. 7: Multinucleated giant cell
DISCUSSION
Preoperatively, every effort should be made to reach a diagnosis because this will help the surgeon to plan the surgery. Ultrasonography can be used as the first method to diagnose a tumor and can provide useful information on tumor vascularity, tumor size, and its relationship to the surrounding tissue. On ultrasonography, GCT-TS appears as a solid homogeneous hypoechoic mass GCT-TS is a benign soft tissue tumor of the limbs that arises from the complex of the tendon sheath and periarticular soft tissue of small joints [6].
The diagnostic approach to GCT-TS involves a multimodal strategy, integrating clinical, radiological, and histopathological findings to differentiate it from other soft tissue neoplasms. Ultrasonography serves as a preliminary non-invasive tool, offering insights into the tumor's vascularity, size, and relation to adjacent structures. The literature review, comprising two case series and multiple case reports, underscores the rarity of foot-involved GCT-TS, with a predilection for the forefoot and a notable recurrence risk post-excision [7].
The therapeutic regimen for GCT-TS emphasizes surgical excision, with the goal of complete tumor removal to minimize recurrence. The presented case's extensive size and prolonged history highlight the importance of early detection and intervention in managing GCT-TS.
A PubMed and Medline search of the topic for articles in the English language has revealed two case series and 12 case studies. The first series of 17 patients was collected retrospectively over 17 y. The second was also a retrospective study of 20 patients treated over 5 y. This is in keeping with GCT-TS being an uncommon condition.
The most common site of occurrence was originally described as the great toe. Wang et al., however, presented a group of 30 patients presenting for ultrasound of GCT-TS, of which seven (23.3%) were foot cases. Most of these occurred in the forefoot [8]. A review of the articles in the orthopaedic literature gave us 49 cases to evaluate the anatomic site of origin. The forefoot had 32 cases (65%), of which 81% occurred on the medial side. The midfoot had four cases (8%) and the hind foot 11 cases (22%). There were a further two cases that crossed anatomical boundaries. The first case which involved the flexor digitorum longus tendon and crossed the forefoot and midfoot with a 12 y history. The second case involved a longstanding large tumour reported in the extensor digitorum longus tendon, which crossed anatomical boundaries of the hindfoot, midfoot and forefoot [9]. Venkateswaran et al. stating that cytodiagnosis is now possible. Cytology findings generally mirror the features on histology as he found in a 20-case series [10].
CONCLUSION
GCT-TS is an uncommon condition in the foot and ankle. It presents as a mass in the foot and ankle, and making a definitive diagnosis is difficult without histology. Clinical features are usually of a slow-growing mass that may cause compressive symptoms. Our case report showed the typical features. However, because of the longstanding nature of the case, our patient presented with an unusually large mass.
FUNDING
Nil
AUTHORS CONTRIBUTIONS
All the authors have contributed equally.
CONFLICTS OF INTERESTS
Declared none
REFERENCES
Noailles T, Brulefert K, Briand S, longis PM, Andrieu K, Chalopin A. Giant cell tumor of tendon sheath: open surgery or arthroscopic synovectomy? A systematic review of the literature. Orthop Traumatol Surg Res. 2017;103(5):809-14. doi: 10.1016/j.otsr.2017.03.016, PMID 28428036.
Fraser EJ, Sullivan M, Maclean F, Nesbitt A. Tenosynovial giant-cell tumors of the foot and ankle: a critical analysis review. JBJS Rev. 2017;5(1):e4. doi: 10.2106/JBJS.RVW.16.00025, PMID 28135228.
Gibbons CAS, Cooke PH, Athanasou NA, Gibbons CL, Khwaja HA, Cole AS, Cooke PH, Athanasou NA. Giant-cell tumour of the tendon sheath in the foot and ankle. J Bone Joint Surg Br. 2002;84-B(7):1000-3. doi: 10.1302/0301-620X.84B7.0841000.
Zhang Y, Huang J, Ma X, Wang X, Zhang C, Chen L. Giant cell tumor of the tendon sheath in the foot and ankle: case series and review of the literature. J Foot Ankle Surg. 2013;52(1):24-7. doi: 10.1053/j.jfas.2012.09.008, PMID 23085383.
Jaffe HL, lichtenstein l, Suro CJ. Pigmented villonodular synovitis, bursitis and tenosynovitis. Arch Pathol. 1941;131:731-65.
O’Keefe RJ, O’Donnell RJ, Temple HT, Scully SP, Mankin HJ. Giant cell tumor of bone in the foot and ankle. Foot Ankle Int. 1995;16(10):617-23. doi: 10.1177/107110079501601007, PMID 8574373.
Kotwal PP, Gupta V, Malhotra R. Giant-cell tumour of the tendon sheath: IS radiotherapy indicated to prevent recurrence after surgery? J Bone Joint Surg Br. 2000;82-B(4):571-3. doi: 10.1302/0301-620X.82B4.0820571.
Zhang Y, Huang J, Ma X, Wang X, Zhang C, Chen L. Giant cell tumor of the tendon sheath in the foot and ankle: case series and review of the literature. J Foot Ankle Surg. 2013;52(1):24-7. doi: 10.1053/j.jfas.2012.09.008.
Guryel E, Coleridge S, Bendall S. Unusual presentation of a giant cell tumor of the tendon sheath in the foot. J Surg Orthop Adv. 2004;13(2):110-11. PMID 15281408.
Iyer VK, Kapila K, Verma K. Fine-needle aspiration cytology of giant cell tumor of tendon sheath. Diagn Cytopathol. 2003;29(2):105-10. doi: 10.1002/dc.10319, PMID 12889051.